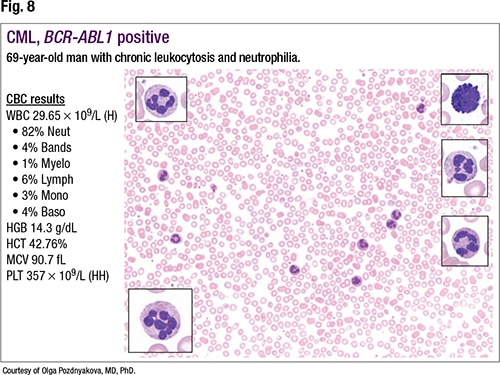

The p190 fusion is seen in less than five percent of CML cases. “However, it is commonly seen in B lymphoblastic leukemias, but unlike the most typical p210, those patients present with monocytosis rather than granulocytosis,” she said. “And those patients have a very poor response to imatinib,” and often evolve to accelerated or blast phase.
Also seen in less than five percent of cases is p230, and patients tend to present with a low WBC count, neutrophilia without left shift, mild symptoms, and often an increased platelet count. “Similar to p210, these patients have an excellent response to TKIs and almost never go into accelerated or blast phase.” CML with p230 can imitate other MPNs, she warned, such as CNL, essential thrombocythemia, or primary myelofibrosis.
Returning to the case of the 69-year-old male who presented with chronic leukocytosis and neutrophilia, Dr. Pozdnyakova revealed the first RT-PCR results, which didn’t show BCR-ABL1 mRNA (B3A2, B2A2, or E1A2), or p210 or p190. “Routinely we only test for p210 and p190,” she said, because p210 is most common in CML and p190 is the common fusion seen in B lymphoblastic leukemia. Because they had not tested for p230, they did not rule out CML.
The next steps, she said, are to wait for a karyotype result, perform a next-generation sequencing analysis that would allow them to find somatic mutations in multiple genes associated with other myeloproliferative neoplasm diagnoses, and perform a bone marrow biopsy.
“NGS plays an essential role in an MPN workup, allowing us to distinguish a reactive from a clonal neoplastic condition,” Dr. Pozdnyakova said. “And while there are no official diagnostic mutations, there are several phenotype-associated mutations that allow us to make a correct diagnosis, such as for Ph-negative MPNs.” For those, she said, “We’ll look for JAK2, CALR, MPL mutations. A lot of cases of chronic neutrophilic leukemia are associated with CSF3R mutation. Atypical CML tends to be associated with SETBP1 or ETNK1 mutation.” And chronic myelomonocytic leukemia has a “whole slew of mutations, with ASXL1, SRSF2, RUNX1, and RAS/CBL the most common.”
“NGS plays an essential role in an MPN workup, allowing us to distinguish a reactive from a clonal neoplastic condition,” Dr. Pozdnyakova said. “And while there are no official diagnostic mutations, there are several phenotype-associated mutations that allow us to make a correct diagnosis, such as for Ph-negative MPNs.” For those, she said, “We’ll look for JAK2, CALR, MPL mutations. A lot of cases of chronic neutrophilic leukemia are associated with CSF3R mutation. Atypical CML tends to be associated with SETBP1 or ETNK1 mutation.” And chronic myelomonocytic leukemia has a “whole slew of mutations, with ASXL1, SRSF2, RUNX1, and RAS/CBL the most common.”

